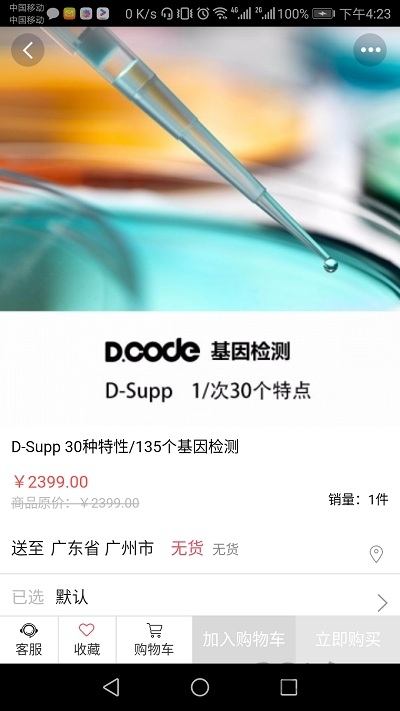
精智tpm软件

精智tpmapp是一个超级超级好用又实用的商务办公类应用系统。由阿尔卑斯系统集成(大连)有限公司官方开发,带来超多优质服务内容,多元化的功能帮助我们用户解决多元化的问题,随时智能监测设备,全面提升整体效率!让工作更轻松!
智能工具类软件。主要服务于企业内部的一些智能设备,可以让企业更加准确掌握设备状况,设置工作模式,可以统计工作数据,维修和改善设备工作性能,结合智能分析,预防事故发生,延长设备寿命,实现降本增效。
帮助用户能够智能的管理各项资产,帮助用户智能的分析每一项收入数据。
充满多元化的服务,可以让各种企业更好的使用,帮助我们完成资产管理。
只需要填写自己的视频资料就可以登录使用,更加的快捷,没有门槛限制。
在设置中心里面可以根据自己的个人使用情况开启个性化模式,更加好操作。
在这个功能齐全的平台上,给用户提供了各种重要的管理工作的工具。
众多的功能可以让用户们随时随地办公,更加的方便快捷,享受一个智能的办公模式。
让用户们可以随时随地在线办公,完成自己的工作,还可以让更多的员工享受便捷在线打卡。
各项功能都可以免费使用,让用户能够在这里快速的完成工作。
首页里面有独特的工作台和资产管理以及备件管理等不同的功能。
重要的文件都可以在这里进行上传,可以帮助用户可以很好的保存。
阿尔卑斯阿尔派集团是一家为客户提供多元化产品与服务的全球供应商,拥有员工 3 万 8 千余名,下属企业 100 余家。集团以日本为中心,在美洲、亚洲、中国各地开展开发、生产、销售业务,在世界各个国家建立地域社会信赖关系,向国际市场提供卓越超群的产品和服务。
阿尔卑斯系统集成(大连)有限公司(简称“alsi”)是日本阿尔卑斯系统集成株式会社于 2005 年在中国投资的全资子公司。公司秉承在制造业现场培植的「精工细作」理念,提供制造业、车载等多元解决方案和全方位服务。
多年来,alsi 坚持 " 客户为本、和谐共赢 " 的价值观,积极践行社会责任,主动挖掘客户潜在需求并提供超越客户期待的系统服务及解决方案,在发展中不断进化,为客户持续创造价值。
修复已知bug。
优化用户体验。